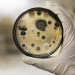
Bild 6

TM Wissen
Reaktorunfall als Härtetest - Roboter sollen retten, wo Menschen sterben würden (Österreich, 2025)
Nahaufnahme des Wiener Schnitzel während Servus TVs "TM Wissen"
Bildauswahl:

Nahaufnahme des Wiener Schnitzel während Servus TVs "TM Wissen"

Kampfroboter während "TM Wissen".

Makroaufnahme von Safran während Servus TVs "TM Wissen".

Radioaktives Symbol während "TM Wissen".

Schimmelpilz während Servus TVs "TM Wissen".
Schimmelkutur auf Laborteller während Servus TVs "TM Wissen".

Fabrikarbeiter trägt Gasmaske und radioaktiven Schutzanzug während "TM Wissen".

Safrangewürz am Löffel während Servus TVs "TM Wissen"

Portrait von Gernot Grömer während Servus TVs Terra Mater Wissen im Terra Mater Wissen Studio in Salzburg am 9. Februar 2024.

Stillgelegtes Atomkraftwerk Zwentendorf während Servus TVs "TM Wissen".

Koch mit fertigem Wiener Schnitzel während Servus TVs "TM Wissen".

Roboterhand während "TM Wissen".

Mündung des Meeres Neunauge während "TM Wissen".

Schimmel in Agarplatte während Servus TVs "TM Wissen"

Koch mit fertigem Wiener Schnitzel während Servus TVs "TM Wissen".

Nahaufnahme Koch mit fertigem Wiener Schnitzel während Servus TVs "TM Wissen"

Safranblüte während Servus TVs "TM Wissen".

Roboterhand und Menschliche Hand während Servus TVs "TM Wissen".

Neunauge während Servus TVs "TM Wissen".
Übersicht
Themen
Details
Hinweis
3 weitere Sendetermine
- in Kalender eintragen
in Kalender eintragen
-
Sendung eintragen in:
Kalender
Google Kalender
-
-
Sendung hinzufügen
zum Merkzettel hinzufügen
-
+ Sendung als TV-Agent einrichten
als TV-Agent einrichten
-
Freunde per Email informieren
per Email informieren
-
in Website einbetten
- 3 weitere Sendetermine
weitere Sendetermine

